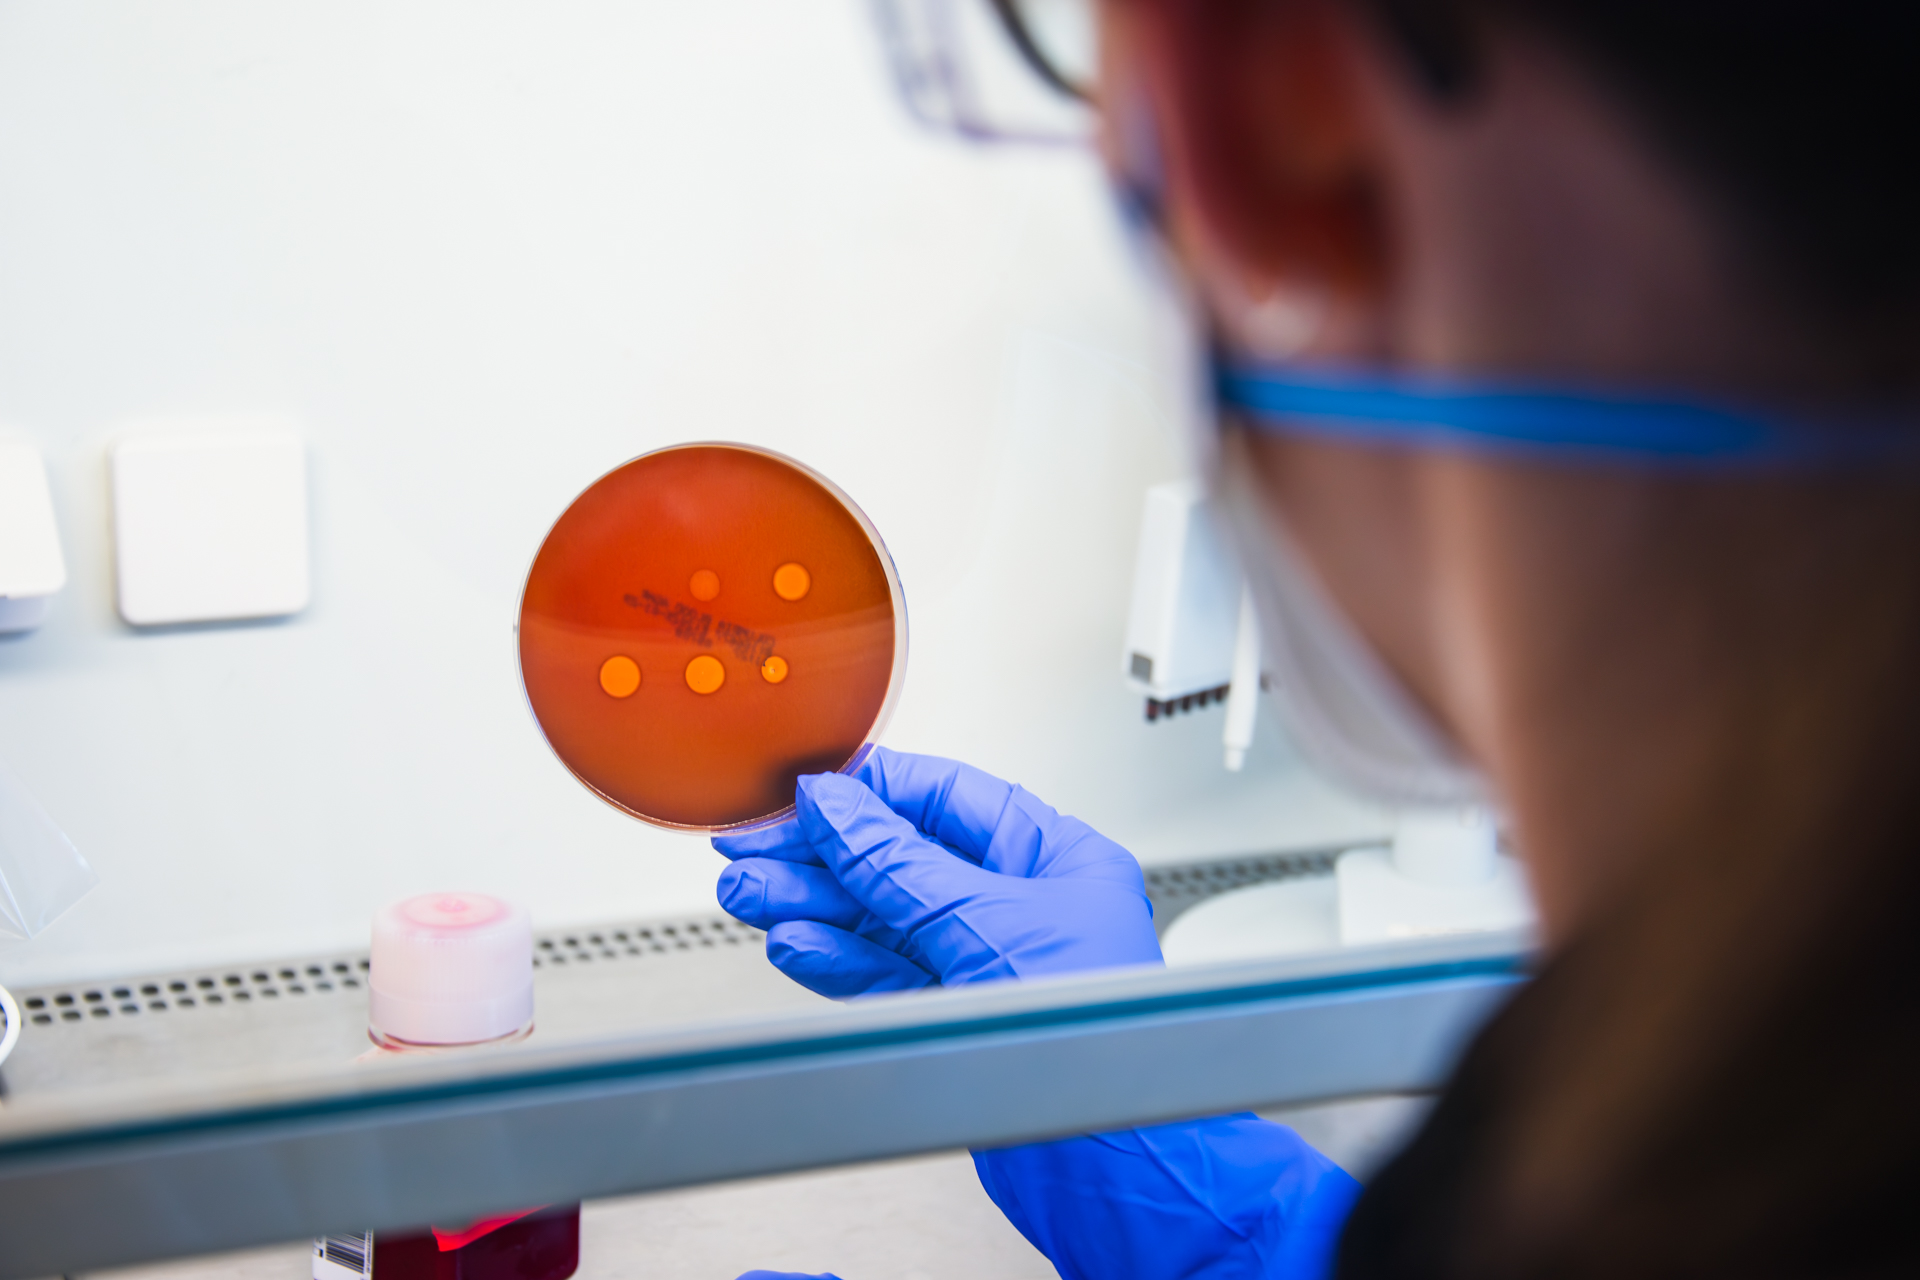

Beschleunigen Sie Ihre Assayentwicklulng für Toxine und Drogen
In einer Welt, in der die Sicherheit von Lebensmitteln und die Überwachung von Toxinen und Drogen immer wichtiger werden, bieten wir Ihnen innovative Lösungen, um Ihre Forschung effizient voranzutreiben. Unser Expertenteam hebt Ihre Forschung auf das nächste Level – von der Problemerkennung bis zur Anwendung. Wir bieten maßgeschneiderte Analyse- und Testlösungen, die Zeit sparen, Kosten senken und regulatorische Anforderungen erfüllen. Mit modernen, tierfreien Technologien ermöglichen wir die schnelle Identifikation und Überwachung lebensmittelrelevanter Risiken – sowie Drogen. Ob zellfreie Proteinsynthese, Hochdurchsatz-Screenings oder Schnelltests: Wir liefern valide Daten und integrierbare Workflows für Labor, Produktion und Vor-Ort-Einsatz. So stärken Sie Qualitätssicherung, Verbraucherschutz und Prozesssicherheit – nachhaltig und effizient.
Wir bieten
- Herstellung und funktionelle Charakterisierung von Lebensmitteltoxinen als Referenzmaterialien und für Assay-Entwicklung.
- Hochdurchsatz-Screenings und Vergleichsstudien mit nahtloser Integration in Ihre QS-Prozesse.
- Entwicklung maßgeschneiderter Assays inklusive digitaler Auslese- und Datenreporting-Lösungen.
- Einfache, schnelle Point-of-Need-Tests (z. B. semi-quantitativer THC-/CBD-Schnelltest) für robuste Entscheidungen vor Ort.
Für weitere Informationen oder eine individuelle Beratung zu unserer Synthese und Charakterisierung von Lebensmitteltoxinen sowie zu unseren THC-/CBD-Schnelltests kontaktieren Sie uns gerne. Wir freuen uns darauf, Ihre Forschung zu unterstützen!
 Fraunhofer-Institut für Zelltherapie und Immunologie, Institutsteil Bioanalytik und Bioprozesse IZI-BB
Fraunhofer-Institut für Zelltherapie und Immunologie, Institutsteil Bioanalytik und Bioprozesse IZI-BB